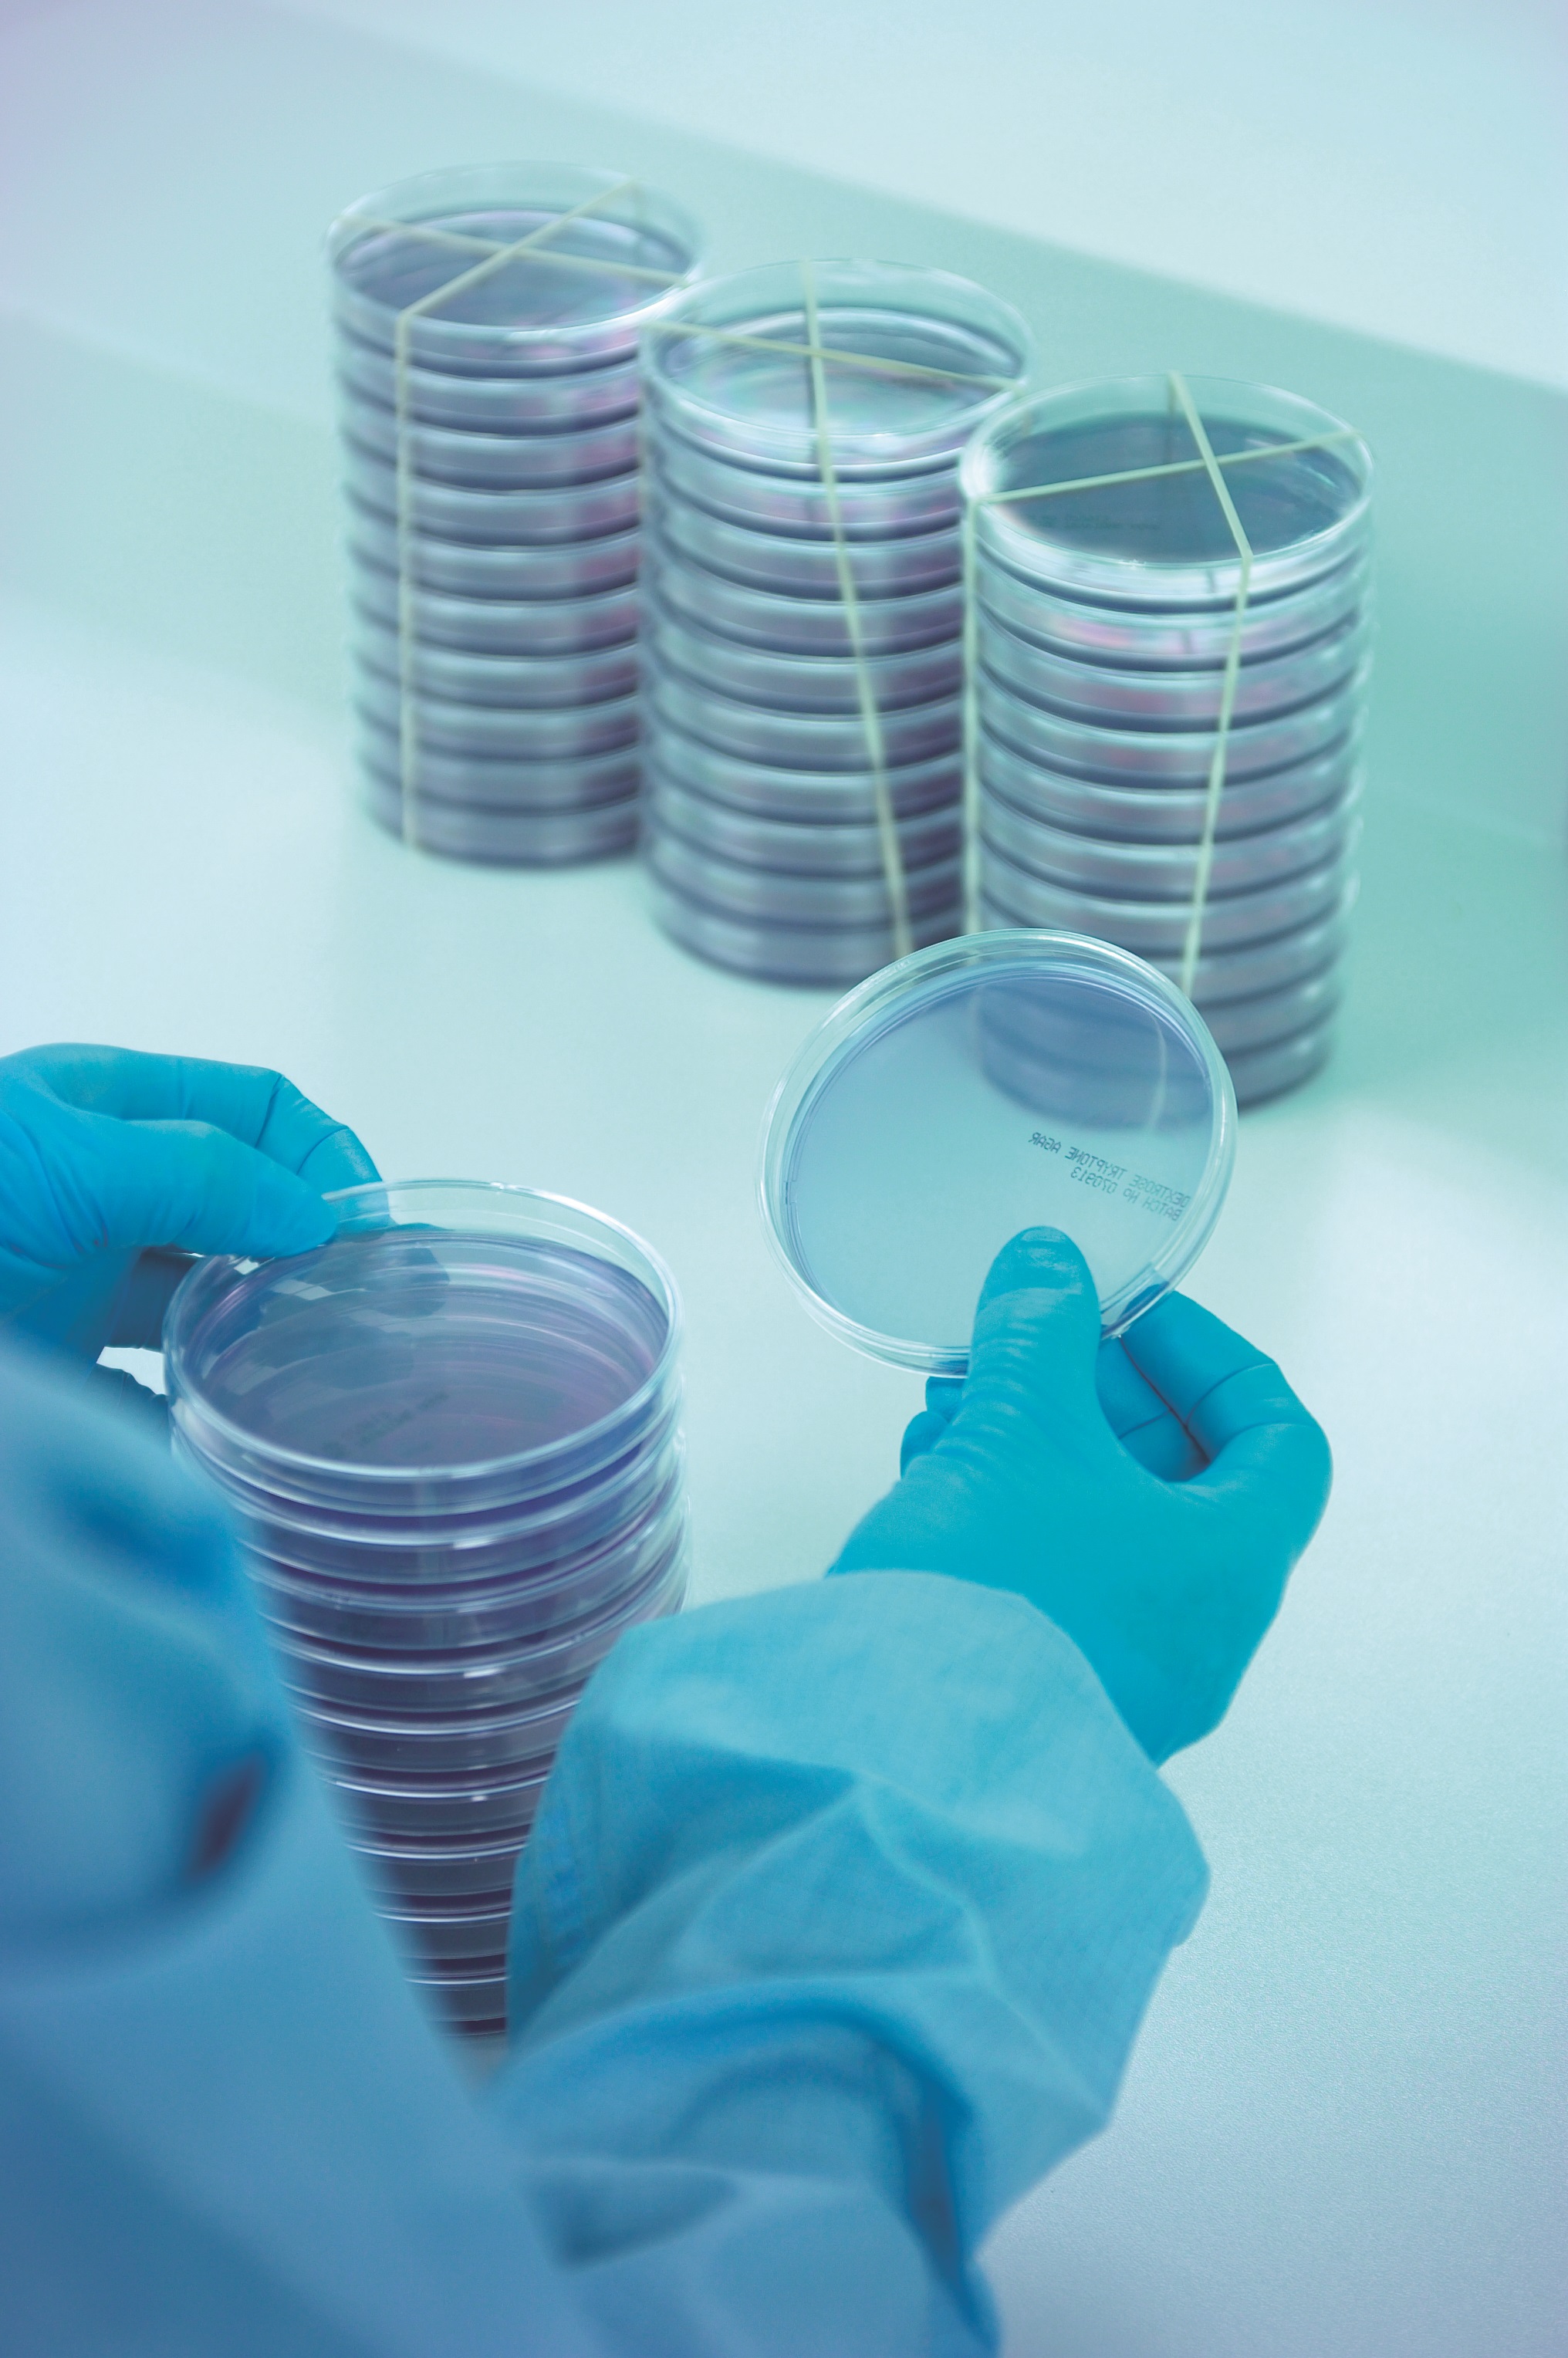

The use of pass-through boxes (PTBs) for the transfer of materials is an absolutely essential part of any biopharmaceutical facility's controlled environments. To understand the types of PTB and the considerations for typical GMP application, read Saurwalt and Vissers' "The basics of PTB design and performance testing" in Cleanroom Technology's October issue. This article delves into a typical application for a GMP ATMP cleanroom situation. The design study, proof of concept tests and qualification tests of a 'continuous flow' pass through box in an actual project show it is capable of effectively recovering 100:1 within 2 minutes after opening.
The all-important Annex 1, as part of EU GMP, applies to the manufacture of sterile products and its purpose is to 'prevent microbial, particulate and pyrogen contamination in final product'. These principles can be applied to other products such as certain liquids, creams, ointments, etc, where control and reduction of contamination is important.
The draft suggest airflow patterns and complex gas flow paths should be considered
The Annex states that the manufacture of steriles is subject to specific requirements to minimise contamination risk and that the key areas are: facilities; equipment and process design according to Good Manufacturing Practice (GMP); personnel with regards to qualifications & experience; and processes & monitoring.
It also states that the principles of quality risk management (QRM) should be used and that a connected contamination control strategy (CCS) should be established. The CCS should directly influence the environmental monitoring programme (EM) deployed.
Continuous EM in Annex 1
EM is an established method used by manufacturers in pharma and healthcare industries, within the manufacture of advanced medicinal products, and increasingly within cosmetics and toiletries. The latest EU GMP Annex 1 draft revision calls for continuous EM in sectors with stringent environmental control and which carry a risk to public health should they the manufacturing be contaminated. Continuous EM is the most effective way of reducing contamination risk, which is why these latest regulations now place such a strong emphasis on its more widespread use.
Currently, the level of environmental monitoring conducted during sterile product manufacture is left at the discretion of the manufacturer. However, the guidance for which action level is required is based on the type of products manufactured and the intended use of the facility, which covers a broad spectrum of actions.
The new Annex 1 revision emphasises the importance of the concept of continuous EM. These new guidelines give far more insight into best EM practice and outline a range of specific techniques to align continuous EM programme with a CCS. Techniques include monitoring of viable and non-viable particulates, as well as aseptic process simulations. The new guidelines also now strongly advise that airflow patterns and complex gas flow paths should also be considered, and that as part of the quality risk management approach risk assessments be re-evaluated when maintenance activities are carried out.
The draft also contains a ‘utilities’ chapter
There are several benefits to manufacturers for making the transition to continuous EM in line with the latest revision of Annex 1. The core benefit being the reduced risk of contamination in grade A environments, such as filling rooms and other areas, to guarantee production of safe medicinal products.
By adopting a robust continuous EM programme, businesses can secure both immediate and long-term benefits. In the short-term, the regular and accurate contaminant readings from facilities not only provide detailed information about potential risk sources in the manufacturing process, but also enable these risks to be dealt with more rapidly. In the longer-term, by enabling effective monitoring of both viable and non-viable microbiological entities, continuous EM prevents disruption to manufacturing processes. This in turn supports company growth and strengthens industry reputation.
To achieve effective continuous EM programmes in the long-term, manufacturers should be able to demonstrate that the techniques they implement can maintain a sterile environment indefinitely. Processes used for this must be substantiated with detailed rationale and validation reports, and the information gathered should be used to make improvements.
Moving to continuous
The first step that manufacturers should take when planning a new continuous EM programme is to conduct an in-depth audit of every aspect of their manufacturing facilities. This should include details of all equipment and processes employed at every stage of the manufacturing process, as well as current protocols for clean room staff in all areas of production.
Other aspects that must be evaluated at this stage include the effectiveness of detection systems in alerting operators to ongoing contamination, training and behaviour of staff at facilities and the suitability of current SOPs. The species of microorganism that have been previously recovered from the facility should also be assessed.
The comprehensiveness of a manufacturer's current EM programme should also be evaluated. This entails the compilation of detailed reports on the methods and frequency of monitoring conducted, and recording when any changes to procedures or equipment are made. Information on viable and non-viable particulates, pressure differentials, temperature and humidity, direction of air flow and surface microbial contamination should all be contained within these reports.
Once a manufacturer has identified and addressed any potential weak points in their current programme, the next stage is to find new equipment and protocols.
A holistic programme
It is important that continuous EM programmes are tailored to suit individual facilities, taking into consideration the size of the business and the sector in which they operate. The most effective programmes encompass a combination of monitoring techniques and equipment to minimise contamination risk. For example, monitoring of surfaces is important for adherence to the revised Annex 1 guidelines, and can be achieved using a combination of contact plates and swabs. Gases used during manufacturing should be sampled for contamination, and their associated containers should also be assessed for sterility.
The new revision sets manufacturers a target of zero
To reduce contamination from external sources and minimise cross contamination, comprehensive PPE should also be provided to staff, including gloves, face masks, hair coverings and garments.
The new draft also contains a 'utilities' chapter, outlining required equipment and highlighting the need for the regular monitoring of equipment that may directly or indirectly come into contact with a sterile product. This includes water systems, steam used for sterilisation, compressed gas, as well as vacuum and cooling systems.
All of these factors need to form a part of that CCS mentioned earlier to form a series of linked events and measures to deliver collective effectiveness. Equally importantly, is that this strategy needs regular review.
The importance of continuous

The measurement of the microbial contamination of air is fundamental to any programme, and there are several methods available to manufacturers, which are based on passive and active monitoring.
Passive methods include use of gamma-irradiated settle plates (shown on p22), which are petri dishes containing culture media that are exposed to air, incubated and then checked for microbial growth over time. Active air monitoring can be conducted in two ways - through air sampling or via continuous air monitoring.
It is worth noting that 'sampling' devices are those which facilitate rapid cubic metre samples and are portable so that multiple locations can be sampled. However, continuous sampling, or monitoring, is slower and typically used at a fixed point within a critical space, such as the grade A filling area.
Active air sampling devices include sieve-based surface air samplers, which as mentioned are simple, portable devices useful for general background room monitoring. The SAS Super 180 on p21 is an example of such a device. While sieve samplers remain an important part of any EM programme, they can only provide a snapshot of microbial contamination in a given area, meaning that manufacturers cannot meet the requirements of the new Annex 1 revision using these devices alone.
For complete compliance with the latest Annex 1 revision, manufacturers must upgrade to continuous air monitoring. This can be achieved using high efficiency, continuous monitoring devices that use slit-to-agar air sampling which enable continuous, quantitative measurement of microbial air contamination over an extended time period (seen right).
Slit-to-agar microbial air monitors use rotating petri dishes which prevents dehydration because the sampled air is constantly impacting a new section of the agar. This prevents losses in the viability of microorganisms during sampling caused by cell damage or stress, thus increasing biological efficiency. With innovative modular designs now available (e.g. ImpactAir ISO-90 monitoring head), such monitoring devices can be adapted into a range of formats to suit specific deployment needs depending on the application, whilst retaining the knowledge gained over many, many years from using agar based systems.
Aiming for zero
Unlike previous iterations of Annex 1 which set the limit for microbial contamination in grade A environments at an average of less than one colony forming unit (CFU), the new revision sets manufacturers a target of zero. Therefore, new monitoring devices must be capable of detecting as few as one CFU as this level of sensitivity is crucial for compliance.
That said, although the collection efficiency of microbial samplers and monitors is an important factor, it should also be noted that a quoted d50 value is just part of the equation. d50 only refers to the physical collection efficiency relating to particle size, that is the particle size at which 50% collection efficiency is achieved.
The second element is biological collection efficiency relating to microorganism viability and is just as important as d50.
Stepping towards a global standard
Another key factor in the importance of the new EU GMP Annex 1 revision is the fact that it will be also be used by the Pharmaceutical Inspection Co-operation Scheme (PIC/S), the WHO, as well as EU GMP. This revision really represents an important step towards a truly global standard in cleanroom environments.
With the new Annex 1 draft expected to be approved in the near future, if they haven't already done so, it is crucial that manufacturers of sterile medicinal products start the process of evaluating their needs and planning how to transition to continuous EM as soon as possible.
Since regulations on EM are only expected to get tighter, moving to continuous EM and learning how to accurately monitor, report and counter identified risks is now more essential than ever.